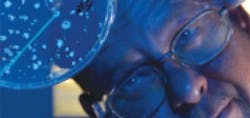
1660602994482 Cg1204apcapps 1660602994482 Cg1204apcapps

Prototyping for Small and Large APC Applications
However, to make the climb, you have to understand that advanced process control (APC) means different things to different people. Before the 1970s, APC typically referred to advanced regulatory control (ARC) which involved feed-forward, ratio, cascade and overrides. During the 1970s, the next generation of APC—model predictive control (MPC)—started to make inroads. Historically, APCs were used to handle production of high-volume, commodity products, and so MPC became the preferred approach to optimize these big-ticket oil and gas, chemical, petrochemicals, refining and other large applications. However, even though MPC still serves its traditional roles, it's also now being considered to help optimize smaller, more specialized processes. Fortunately, just as computers, electronics, software and other devices are enabled by faster, more powerful and cheaper microprocessors, MPCs have been coming down in price lately, too. Unfortunately, it can still be difficult to successfully argue for using MPC in smaller applications, mainly because so many people think it's too costly, and will take too long to be worthwhile.
DuPont (www2.dupont.com) has been using ARC applications and its rigorous modeling and simulations for many years, but lately some DuPont engineers have been using rapid prototyping methods to help choose, implement and gain MPC's benefits in smaller applications where it makes economic or operational sense. To aid these efforts, DuPont is using the recent integration between Aspen Technology Inc.'s (www.aspentech.com) aspenOne APC software and its Hysys dynamic modeling and simulation software to refine and increase its smaller-scale MPC implementations by 450%.
MPC via the Internet
"Basically, this capability facilitates appropriate use of MPC in more applications, which is part of DuPont's best practices and Six Sigma approach," says Phillip "Dave" Schnelle, principal consultant in the Process Dynamic and Controls Group in the Engineering Technology division at DuPont. "Rapid prototyping is part of our application development flow for APC. It allows us to screen APC applications and answer the question 'ARC or MPC?' We run Aspen APC on our central server in Wilmington, Delaware, and hook it up to data sources, such as Aspen's standard InfoPlus.21 (IP21) historian and others at any of our hundreds of plants worldwide via a process data connection. We can mock up and prototype MPC applications connect real process data. Using these predictions, we can then show operations 'this is our plant on your current controls, and this would be your plant on APC.'
"For instance, we can sit in our offices and get information from any facility that has IP21, and then use that data to create a models and controllers. The output HMI for the prototype MPC is a web page. The plant engineers can watch what's going to happen in a particular operating situation by pulling up the Production Control web pages for their application. So, without incurring any expense, they can make better decisions about whether it's a good idea to use MPC for their application."
Traditional approaches to MPC can take weeks and cost thousands of dollars. Creating prototype MPC applications and using them for engineer and operator training can make implementing real application more straightforward and more successful in the long run. "Many potential DuPont MPC applications are relatively small, but they can be very lucrative because of increased push rates or energy savings. However, they can be hard to justify because of their size," explains Schnelle. "Rapid prototyping helps us make the 'go or no go' decision. We can quickly test and train on the concept; transfer ideas to the operators; develop MPC models; and do it all without spending a lot upfront. Once we know a project will succeed, much of the design has already been done, and we have most of the application already to go."
Robert Golightly, Aspen Technology's industry marketing manager for APC, adds that, "The novelty in DuPont's efforts is the process they use to choose and justify APC projects. The tradition is to perform detailed engineering studies as part of the justification process for APC. Part of those studies includes an estimation of expected benefits. These studies are time consuming and very expensive. What DuPont is doing is streamlining the process for evaluating, selecting and prototyping MPC applications to the point that it's economically viable for smaller units.
Prototyping Procedure
Figure 1: DuPont secures on-site operating data from web-based remote monitoring devices, delivers it via an OPC connection, and feeds it into Aspen Technology's HYSYS and aspenONE software to create rigorous models and justify advanced process control (APC) in more smaller process applications.
Source: Aspen Technology
- Create a dynamic model of the unit using Hysys;
- Connect the Hysys model to OTS Framework;
- Connect the Aspen Control Platform (ACP) to OTS Framework;
- Make step tests from within Hysys model environment (manipulating the MV, passing MV and CV data to OTS Framework and on to APC;
- Use data collected by ACP during the step test process to create and tune the controller; and
- Connect the ACP controller back to Hysys to develop the business case benefits for using APC on the "virtual process."
"We added an Aspen DMCplus function block to Hysys software, which allows users to see the impact of APC on the unit as they run the simulation. They can also use AspenWatch's real-time monitoring to build calculations that capture the benefits," explains Golightly. "Within the simulation, the monitor is connected to the Aspen DMCplus function block. The simulation is used to generate baseline data and then the controller function block is enabled. The controller can modify the simulation's settings and check for differences, all of which is captured and compared using the monitoring tools. So, instead of taking months to justify an APC project by collecting and analyzing production data, we've been able to help the user create a baseline and compare that to the expected performance with APC in just a couple of days, which enables faster, less costly APC, buy-in from operators at the very start of projects, and much better business decisions.
Rapid Results
Schnelle reports that DuPont began using the IP.21 data connections for rapid prototyping about four years ago. Consequently, while DuPont previously did one or two APC applications per year, its rapid prototyping method is now enabling it to perform 10-20 MPC implementations per year. "These are mostly focused on better control, pushing constraints and saving energy in smaller-scale applications, such as polymer, protein, wet chemical and other production applications," says Schnelle. "Production personnel are usually very conservative, and so our prototypes help convince them that MPC can benefit and improve their operations and can be maintained"
In fact, Schnelle adds the actual performance of many applications with MPC has been even better than their prototypes indicated, and has helped their MPC systems save labor, improve throughput and yield, save energy and minimize waste. "A good prototype can get everyone on the same page, and help drive consensus about which projects are worth going after," says Schnelle. "And, if operators can see their usual tags and data in a simulation, it enables better awareness, and makes it easier to decide if MPC is right for that certain situation."
In the future, Schnelle projects that prototyping may be applied in more of DuPont's batch and biological applications.
About the Author

Leaders relevant to this article: